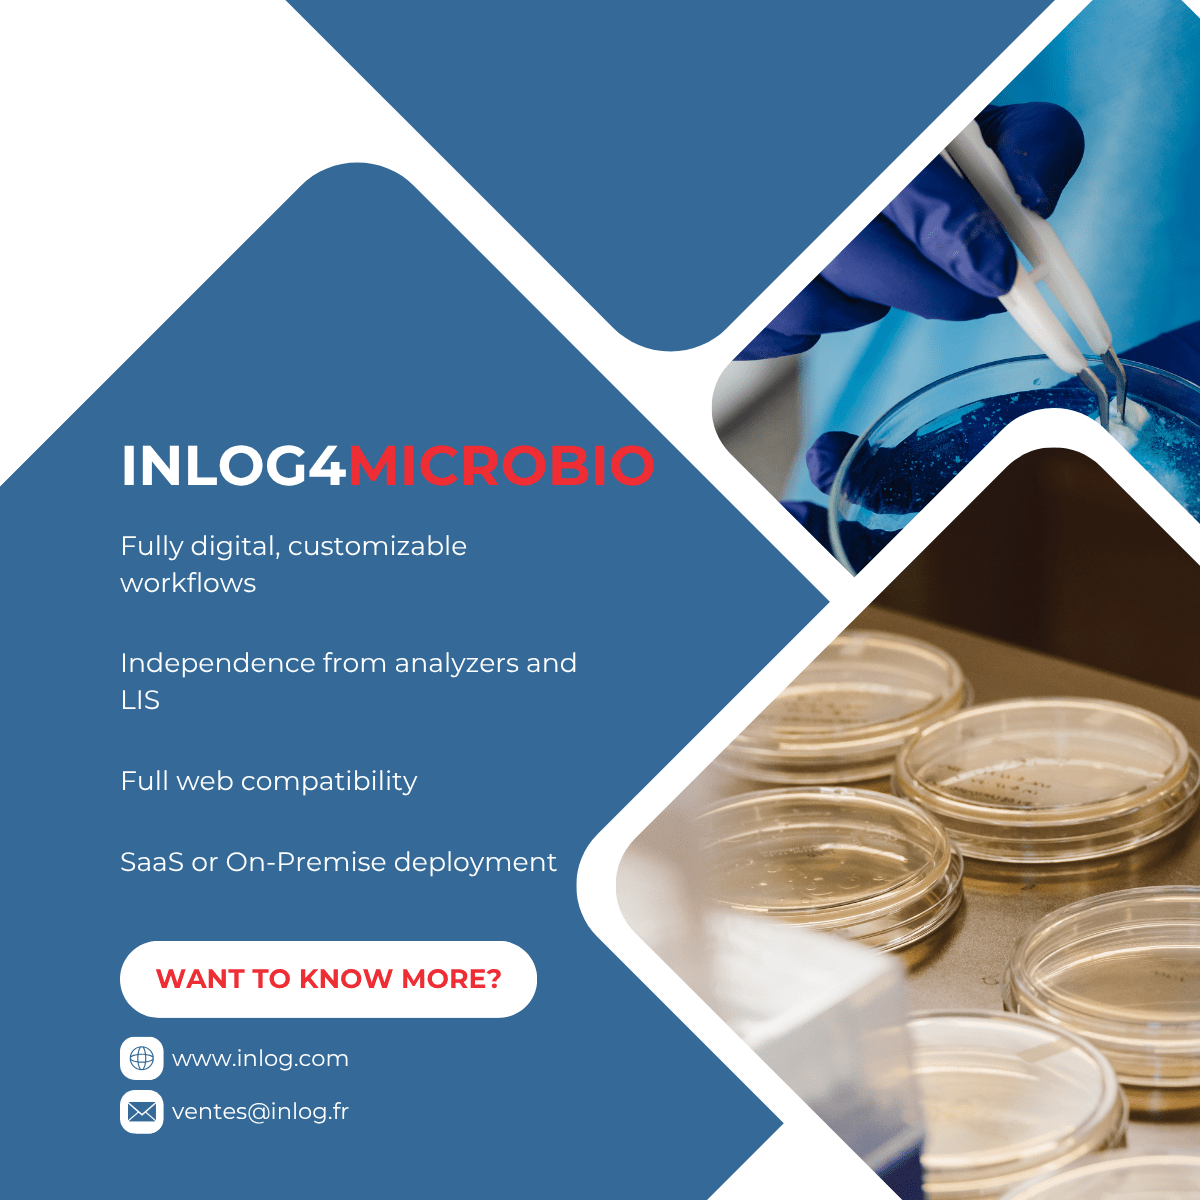

Digitalizing Microbiology with Inlog4Microbio
Digitalizing Microbiology with Inlog4Microbio: Simplify, Optimize, Secure
Digitalizing Microbiology with Inlog4Microbio: Simplify, Optimize, Secure
At Inlog, we believe microbiology labs deserve tools that truly match their challenges. That’s why we created
Inlog4Microbio — a next-generation middleware that fully digitalizes bacteriology, 100% paperless.
What it brings to your lab
• Fully digital, customizable workflows
• Independence from analyzers and LIS
• Full web compatibility
• SaaS or On-Premise deployment
With Inlog4Microbio, you can structure, centralize, and secure the entire bacteriological cycle — from sample to validation — while removing traditional technical constraints.
The result? Greater efficiency, faster results, and a streamlined work environment for your teams.
Inlog4Microbio: reinventing microbiology for tomorrow’s laboratories.
Discover all our news on LinkedIn
#Inlog #Middleware #Microbiology #Inlog4Microbio #Bacteriology #FullWeb